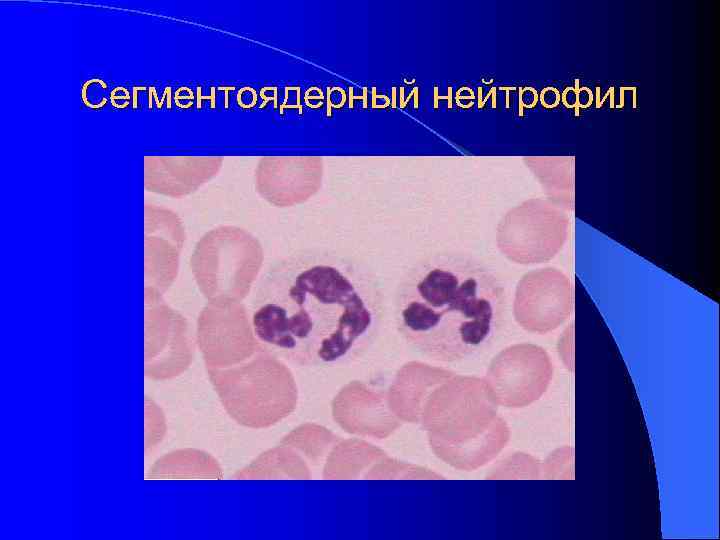
Сегментоядерный нейтрофил Сегментоядерный нейтрофил
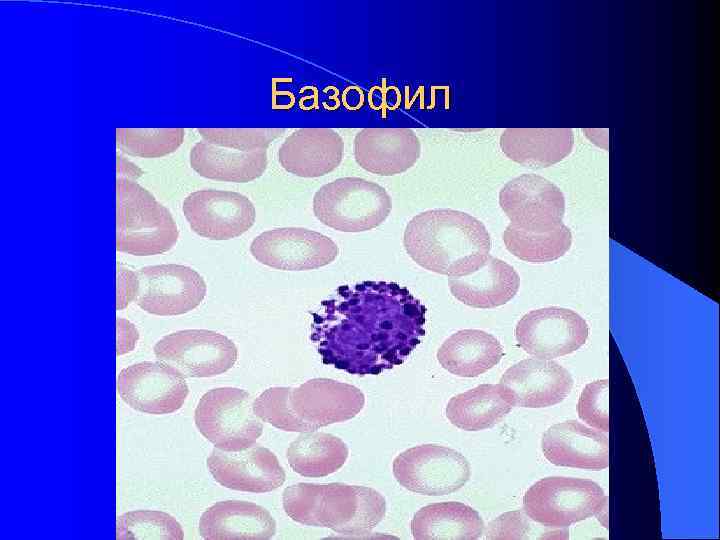
Базофил Базофил

Физиология крови Лейкоциты Профессор Н. В. Ермакова

Л2- Лейкоциты.ppt
- Количество слайдов: 31
Физиология крови Лейкоциты Профессор Н. В. Ермакова
Функции лейкоцитов: l Защитная: – фагоцитоз микроорганизмов; – бактерицидное действие, – антитоксическое действие, – участие в иммунных реакциях l Регенеративное (способствуют заживлению поврежденных тканей) l Участвуют в процессах свертывания крови и фибринолиза l Транспортная (носители ферментов: гистаминазы, кислой фосфатазы, лизосомальных гидролаз)
Лейкоцитозы Норма = 4 -9 х 109/л 4 -9 тыс. /мкл Лейкопении
Лейкоцитозы Физиологические Патологические Пищевой Воспалительные заболевания Миогенный Инфекционные заболевания Эмоциональный Заболевания системы крови При беременности
Физиологические лейкоцитозы 1. Как правило, перераспределительные 2. Не достигают высоких значений 3. Не длительные (кроме беременности) 4. Нет сдвига лейкоцитарной формулы влево
Патологические, или реактивные лейкоцитозы 1. Абсолютные или истинные за счет усиления лейкопоэза 2. Более высокие значения 3. Более длительные 4. Может быть сдвиг лейкоцитарной формулы влево
Лейкопении При повышении радиоактивного фона При лучевой болезни При применении некоторых фарм. препаратов (цитостатиков, сульфаниламидов) При некоторых тяжелых инфекционных заболеваниях (сепсис, милиарный туберкулез)
Виды лейкоцитов
Виды лейкоцитов Лейкоциты Гранулоциты: Агранулоциты: нейтрофилы 45 -70% моноциты 2 -10% эозинофилы 1 -5% лимфоциты 25 -40% базофилы 0, 5 -1%
Нейтрофильные лейкоциты по степени зрелости ядра они делятся на: юные (метамиелоциты) 0 -1% палочкоядерные 1 -5% сегментоядерные 45 -65%
Лейкоцитарная формула - процентное соотношение всех видов лейкоцитов Сдвиг лейкоцитарной формулы влево – увеличение количества юных и палочкоядерных нейтрофилов (при инфекционных, воспалительных заболеваниях, лейкозах)
Юный нейтрофил
Палочкоядерный нейтрофил
Сегментоядерный нейтрофил
Функции нейтрофилов (микрофагов) l Фагоцитоз бактерий и продуктов распада тканей (первыми приходят в очаг повреждения) l Цитотоксическое действие (лизоцим-повреждает стенку бактерий; катионные белки – нарушают дыхание и рост микробов; протеазы и кислые гидролазы –переваривают фагоцитируемые объекты; образование супероксидных ионов и перекиси водорода, повреждающих мембраны клеток) l Секреция веществ стимулирующих регенерацию тканей l Продукция интерферона ( противовирусное действие) По нейтрофилам можно определить пол человека (у женского генотипа барабанные палочки)
Эозинофил
Функции эозинофилов: Основная функция – обезвреживание и разрушение токсинов белкового происхождения, чужеродных белков, а также комплекса антиген-антитело. Продукция фермента гистаминазы, разрушающий гистамин Антипаразитарное действие (цитотоксическое действие на личинку гельминтов)
Базофил
Функции базофилов связаны с содержащимися в них биологически активными веществами: l гепарин препятствует свертыванию крови в очаге воспаления; l гистамин расширяет капилляры, что способствует рассасыванию и заживлению; l гиалуроновая кислота, фактор активации тромбоцитов (ФАТ), тромбоксаны и др.
Агранулоциты: моноциты лимфоциты
Моноцит
Функции моноцитов (макрофагов) l Фагоцитоз (в кислой среде) l Синтезируют: l - компоненты системы комплемента – интерферон – фактор некроза опухолей – интерлейкин l Осуществляют презентацию антигена
Лимфоцит
Функции лимфоцитов: l Осуществляют формирование специфического иммунитета, l синтез защитных антител, l лизис чужеродных клеток, l реакцию отторжения трансплантата, l обеспечивают иммунологическую память
Виды лимфоцитов: Лимфоциты Т-клетки В-клетки О-лимфоциты (тимусзависимые) (бурсозависимые) (нулевые) 60% 25 -30% 10 -20%
Т-лимфоциты l Т-киллеры – разрушают чужеродные клетки; l Т-хелперы – «помогают» , т. е. индуцируют размножение и дифференцировку клеток другого типа; l Т-супрессоры – подавляют иммунный ответ; l Т- клетки иммунологической памяти – обеспечивают «надзор» за поступлением в организм чужеродных агентов.
В-лимфоциты l Взаимодействие В-лимфоцитов с антигеном приводит к превращению их в зрелые (плазматические) клетки. l Плазмоциты продуцируют антитела- иммуноглобулины 5 классов: Ig. M, Ig. G, Ig. A, Ig. E, Ig. D
Понятие о неспецифических механизмах защиты, или неспецифическом иммунитете 1. Естественные барьеры – кожа, слизистые 2. Гуморальные факторы – система комплемента плазмы крови, интерферон, лизоцим и др. 3. Врожденная клеточная защита – фагоциты (гранулоциты и макрофаги), NK-клетки (естественные клетки-киллеры, не обладающие специфичностью к антигену)
Специфические механизмы защиты, или специфический иммунитет l Иммунная система – это органы, ткани, клетки, обеспечивающие механизмы специфического иммунитета. l Органы иммунной системы. Центральные -красный костный мозг (главный источник стволовых клеток) и тимус. Периферические – селезенка, лимфатические узлы, лимфоидная ткань (размножение, специализация иммуноцитов). l Иммунитет – это защита от инфекций, контроль над опухолевыми клетками, реакции на пересаженный орган
l Гуморальный иммунитет – разрушение чужеродных клеток и нейтрализация продуктов их жизнедеятельности путем связывания антител с антигенами. l Эти реакции направлены против внеклеточных бактерий и вирусов
l Клеточный иммунитет – иммунные реакции (уничтожение антигенов) осуществляются эффекторными Т-лимфоцитами (Т- киллерами).

